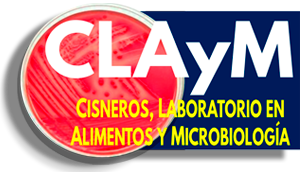
CLAyM
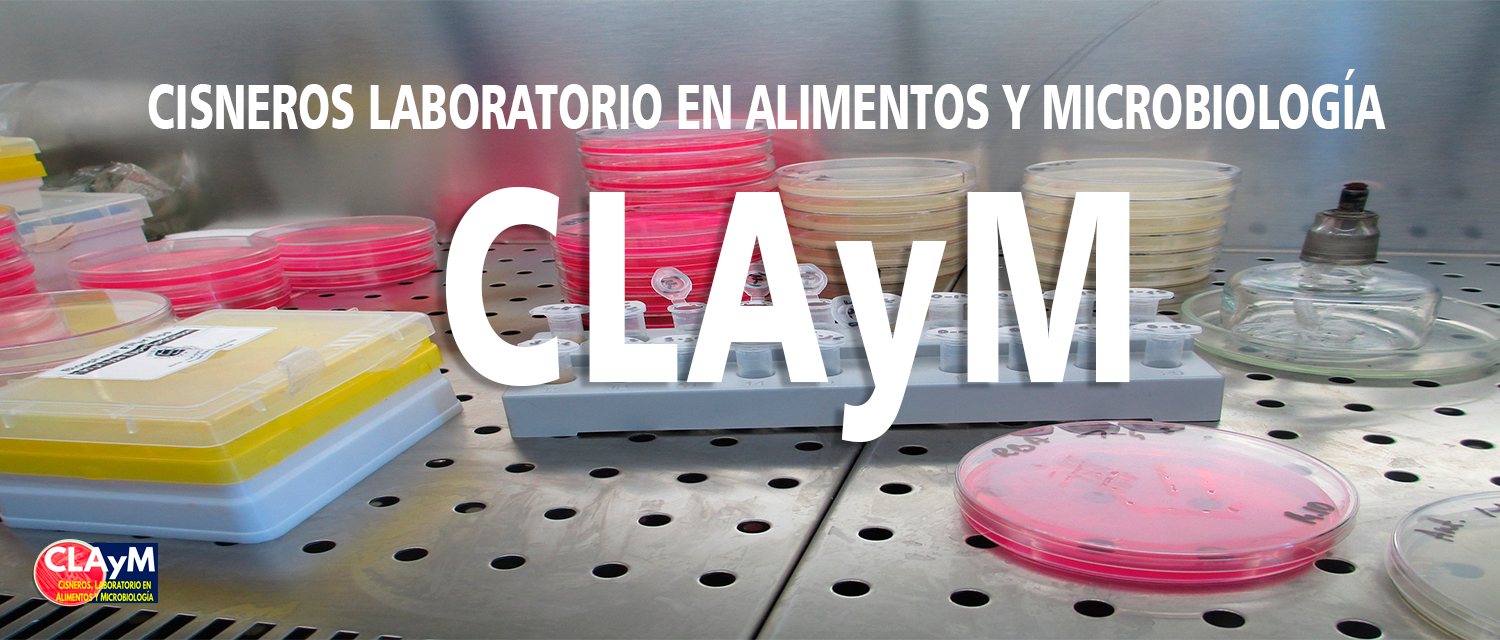
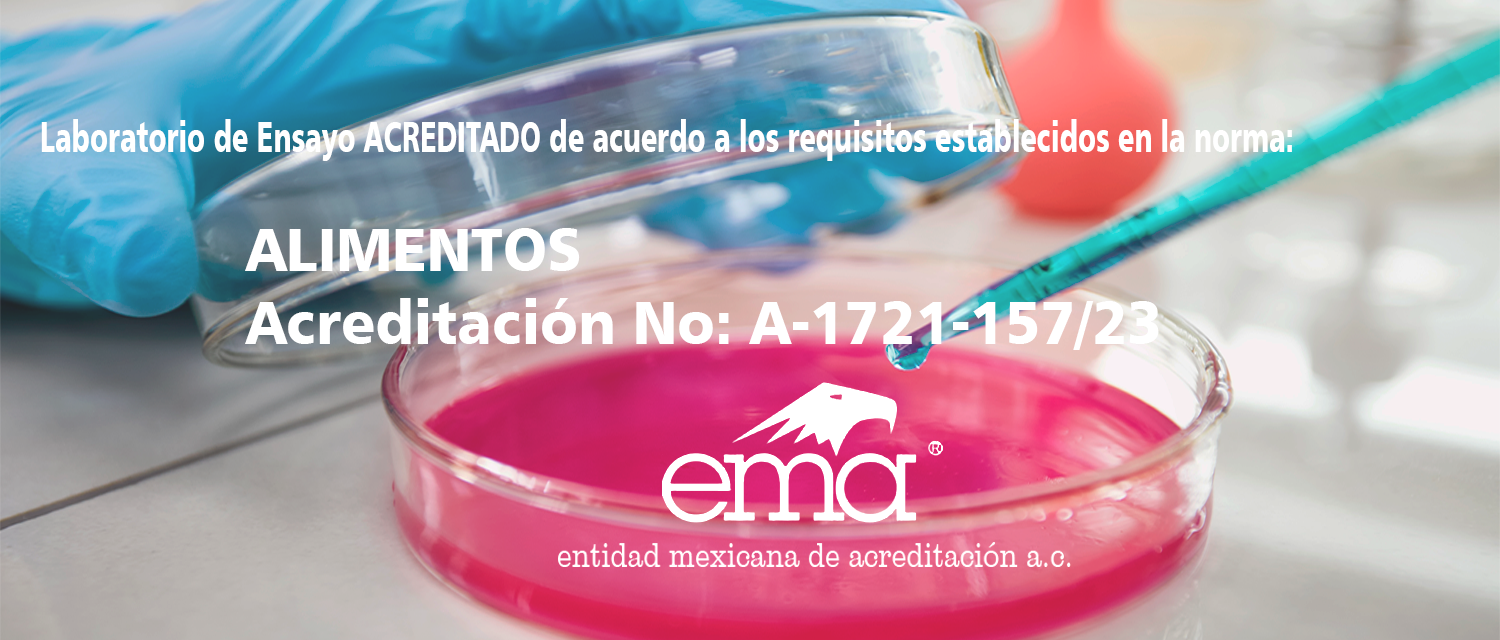

Cisneros, Laboratorio en Alimentos y Microbiología.
Somos un laboratorio con responsabilidad social, que realiza análisis microbiológicos de alimentos a través de procedimientos de calidad, alineados a normativas vigentes, garantizando resultados confiables en tiempos óptimos, que contribuyen a la satisfacción del cliente y a la mejora continua de la empresa.
En laboratorio de análisis microbiológicos CLAyM realizamos pruebas en varias matrices:
Alimentaria, ambiental, superficial, entre otros.
Se cuantifican y califican microbiológicamente las muestras mediante la identificación de los microorganismos.
La credibilidad de sus análisis siempre deberá evidenciarse para empresas de diferentes segmentos, industrias y otros públicos.